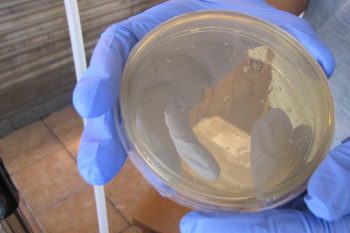

Somos uma empresa especializada na prestação de serviços de análises microbiológicas de alimentos e água, consultoria em segurança alimentar e realização de treinamentos.
Estes programas tornam-se uma ferramenta que visa alcançar os níveis adequados de segurança dos alimentos garantindo sua integridade e a saúde do consumidor.